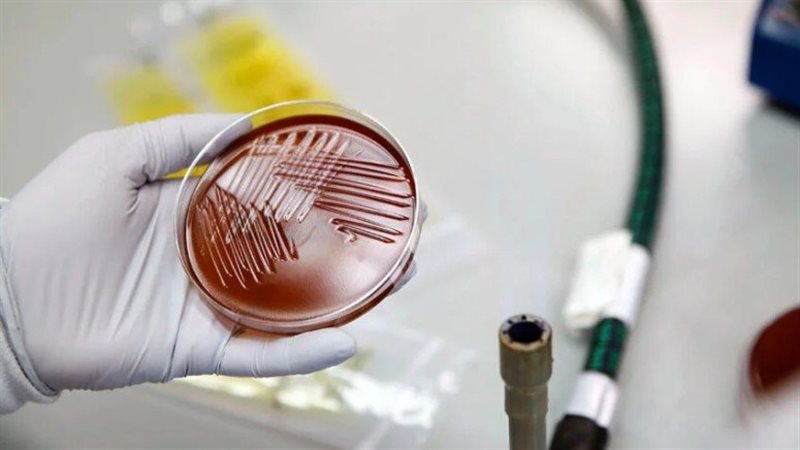

آخر أخبار الصحة.. تطوير أول فحص دم للكشف عن متلازمة التعب المزمن
قال علماء بريطانيون إنهم طوروا أول فحص دم في العالم لتشخيص التهاب الدماغ والنخاع العضلي، المعروف أيضا باسم متلازمة التعب المزمن (ME/CFS).
ولا يوجد حاليًا أي اختبار لهذه الحالة، وعادةً ما يشخص المرضى بناء على الأعراض، مما يعني أن كثيرين منهم قد لا يشخصون لسنوات.
كواليس البحث
وقد فحص العلماء، التابعون لجامعة إيست أنغليا البريطانية، وشركة أوكسفورد بيودينامكس (OBD)، عينات دم من 47 مريضا يعانون متلازمة التعب المزمن، و61 بالغا سليما.
واكتشف الفريق نمطا فريدا يظهر باستمرار في الحمض النووي الخاص بالأشخاص المصابين بمتلازمة التعب المزمن، وهو نمط لا يلاحظ لدى الأصحاء، مما مكنهم من تطوير الاختبار.
وفي تقرير عن الاختبار الجديد، نشر بمجلة الطب الانتقالي، ذكر العلماء أن حساسية الاختبار ودقته في الكشف عن المصابين بمتلازمة التعب المزمن بلغت 92 في المائة.
وقال الباحث الرئيسي البروفيسور ديميتري بشيزيتسكي: «متلازمة التعب المزمن مرض خطير وعائق في كثير من الأحيان يتميز بإرهاق شديد لا يزول بالراحة، نعلم أن بعض المرضى يبلغون عن تجاهل الأطباء أعراضهم، أو حتى إخبارهم بأن مرضهم (وهمي). وفي ظل غياب اختبارات حاسمة، ظل كثير من المرضى دون تشخيص أو بتشخيص خاطئ لسنوات».
وأضاف: «أردنا أن نرى ما إذا كان بإمكاننا تطوير فحص دم لتشخيص هذه الحالة، وقد فعلنا ذلك، يتيح اكتشافنا إمكانية إجراء فحص دم بسيط ودقيق للمساعدة في تأكيد التشخيص، مما قد يؤدي إلى دعم مبكر وإدارة أكثر فعالية لهذه المشكلة الصحية».
ومع ذلك، دعا خبراء آخرون إلى إجراء مزيد من الدراسات لتأكيد هذه النتيجة، وتقييم الاختبار على نطاق أوسع من المرضى، قبل النظر باستخدامه في الممارسة السريرية